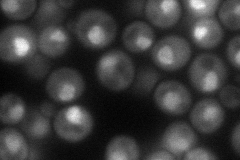
YDR427W
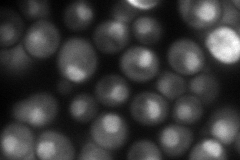
YDR427W
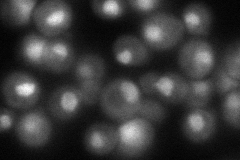
YDR427W
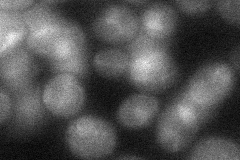
YDR427W

View description
Non-ATPase regulatory subunit of the 26S proteasome, has similarity to putative proteasomal subunits in other species; null mutant is temperature sensitive and exhibits cell cycle and proteasome assembly defects
Localization:
Intensity:
Fold change:
Significance:
-
C’ GFP library in SD

nucleus124.48 -
N' NOP1pr-GFP in SD
nucleolus72.1257 -
N' TEF2pr-mCherry in SD
nucleus114.078 -
N' NATIVEpr-GFP in SD
nucleus85.6299 -
N' TEF2pr-VC and Cyto-VN in SD
nucleus32.4764 -
C’ GFP library in SD+DTT

nucleus111.20.89No -
C’ GFP library in SD+H2O2

nucleus116.210.93No -
C’ GFP library in Starvation Media

nucleus114.470.91No -
C’ GFP library on the background of Pup2-DaMP

nucleus -
C’ GFP library on the background of CCT mutant

nucleus135.0141.08451No
